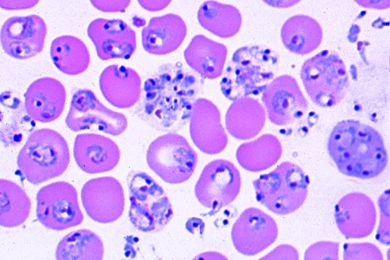
Mikropräparat - Plasmodium berghei, Malaria bei Nagetieren

Zubehör: - Präparatekasten aus Kunststoff für 25 Präparate - wird bei Ihrer Bestellung automatisch mit geliefert und separat berechnet.
Verifizierter Kauf *
Geschrieben von verifizierten Kunden am 31.05.2012
Danke. Alles bestens.
Gutes Produkt
Verifizierter Kauf *
Geschrieben von verifizierten Kunden am 26.07.2007
So hatte ich es erwartet
Danke.Gerne wieder
Verifizierter Kauf *
Geschrieben von verifizierten Kunden am 01.06.2012
bester Service
Alles super gelaufen, gerne wieder!
Verifizierter Kauf *
Geschrieben von verifizierten Kunden am 15.07.2013
Ein wertvolles Stück
Sehr gute Investition für mich selbst :)
Verifizierter Kauf *
Geschrieben von verifizierten Kunden am 17.10.2016
Genial!!
Superschneller Versand, top Qualität, Sehr guter Verkäufer. 5 Sterne *****
Herstellerkennzeichnung
Herstellerkennzeichnung
Name: Johannes Lieder GmbH & Co. KGPostleitzahl: Ludwigsburg
Telefonnummer: +49 7141 921919